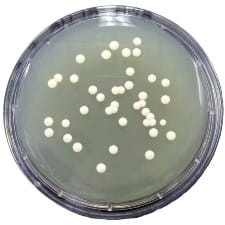
Sabouraud Glucose + Chloramphenicol gotowe podłoże na płytkach kontaktowych

TSA with Disinhibitor PLUS gotowa pożywka na płytkach typu Rodac
• Opakowanie:10 szt.
• Płytki: 90 mm
 Opis
Opis
TSA with Disinhibitor PLUS – gotowa pożywka na płytkach typu Rodac
Profesjonalna pożywka do monitorowania czystości powierzchni
TSA with Disinhibitor PLUS to wysokiej jakości gotowa pożywka mikrobiologiczna w płytkach typu Rodac o średnicy 90 mm. Produkt został zaprojektowany do skutecznego pobierania próbek powierzchni po procesach czyszczenia i dezynfekcji, wspierając dokładne monitorowanie mikrobiologiczne w środowiskach sterylnych i przemysłowych.
Zastosowanie TSA with Disinhibitor PLUS
TSA with Disinhibitor PLUS jest stosowany w kontroli mikrobiologicznej, szczególnie w przemyśle farmaceutycznym, spożywczym oraz placówkach medycznych. Dzięki obecności czterech środków odhamowujących, w tym tiosiarczanu sodu, pożywka skutecznie neutralizuje środki do dezynfekcji powierzchni, umożliwiając odzyskiwanie mikroorganizmów i rzetelną ocenę skuteczności procedur czyszczących.
Kluczowe cechy produktu:
-
Gotowe do użycia płytki Rodac – optymalne rozwiązanie do monitorowania mikrobiologicznego powierzchni.
-
Średnica płytki 90 mm – idealna powierzchnia do skutecznego pobierania próbek.
-
Opakowanie 10 szt. – odpowiednie do systematycznych badań.
-
Neutralizatory środków dezynfekujących – cztery środki odhamowujące poprawiają skuteczność wykrywania mikroorganizmów.
Zalety stosowania TSA with Disinhibitor PLUS
Bezpieczeństwo i stabilność
-
Innowacyjna konstrukcja dna – kopułowy kształt zapobiega wypadaniu agaru z naczynia.
-
Technologia GripFit™ – zapewnia stabilność pokrywy podczas przenoszenia, a jednocześnie ułatwia jej zdejmowanie w trakcie analizy.
Łatwość interpretacji wyników
-
Podział na siatki – dolna warstwa płytki zawiera podziałkę, co ułatwia precyzyjne liczenie jednostek tworzących kolonie (CFU).
-
Raportowanie wyników – ułatwia ocenę, czy poziomy zanieczyszczeń mieszczą się w dopuszczalnych limitach.
Wygodne przechowywanie i transport
-
Możliwość układania w stosy – zapewnia większą stabilność podczas przenoszenia i minimalizuje ryzyko przewrócenia.
-
Redukcja wentylacji – zapobiega nadmiernemu wysychaniu płyt podczas przechowywania.
Precyzja i powtarzalność wyników
-
Zautomatyzowana produkcja – każda płytka zawiera równomiernie rozłożoną warstwę agaru, co gwarantuje spójność wyników.
Dla kogo przeznaczony jest produkt?
TSA with Disinhibitor PLUS to idealne rozwiązanie dla laboratoriów mikrobiologicznych, firm farmaceutycznych, zakładów spożywczych oraz placówek medycznych, które wymagają precyzyjnego i skutecznego monitorowania mikrobiologicznego powierzchni.
Podsumowanie
TSA with Disinhibitor PLUS to innowacyjna pożywka mikrobiologiczna, która ułatwia skuteczne monitorowanie środowisk sterylnych. Dzięki technologii GripFit™, kopułowemu dnu oraz podziałce na siatki, produkt zapewnia precyzyjne i wygodne pobieranie próbek, eliminując ryzyko błędów i zwiększając efektywność analizy mikrobiologicznej.
W powyższym linku znajdą Państwo bazę aktualnych certyfikatów firmy OXOID. Wystarczy wpisać numer LOT zamówionej przez Państwa partii, w celu uzyskania odpowiedniego certyfikatu.
 Koszty dostawy
Cena netto, nie zawiera podatku
Koszty dostawy
Cena netto, nie zawiera podatku
darmowa i wygodna wysyłka
już od 800 zł netto
Najwyższa jakość
produktów potwierdzona certyfikatami
Zakupy 24h na dobę
wygodne i bezpieczne
bezpłatna konsultacja
z ekspertem online